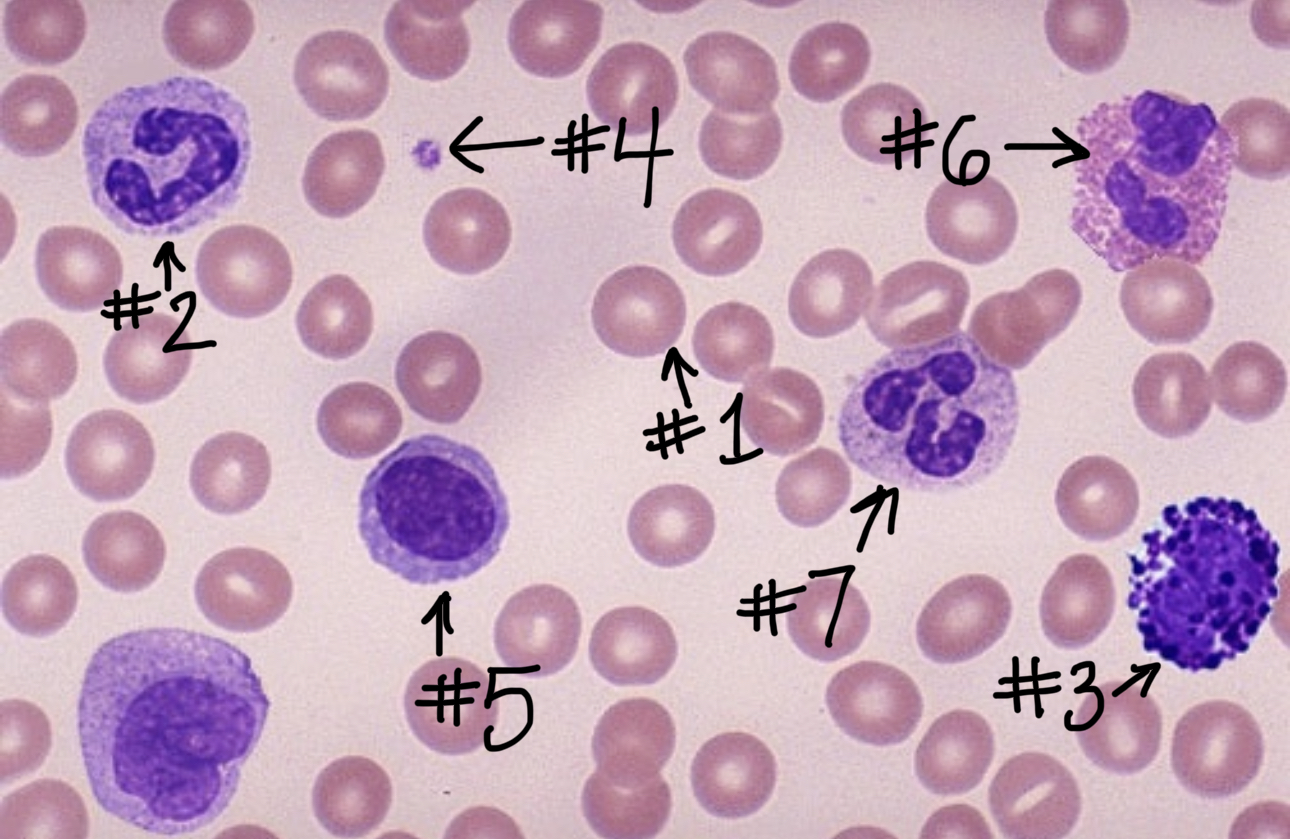
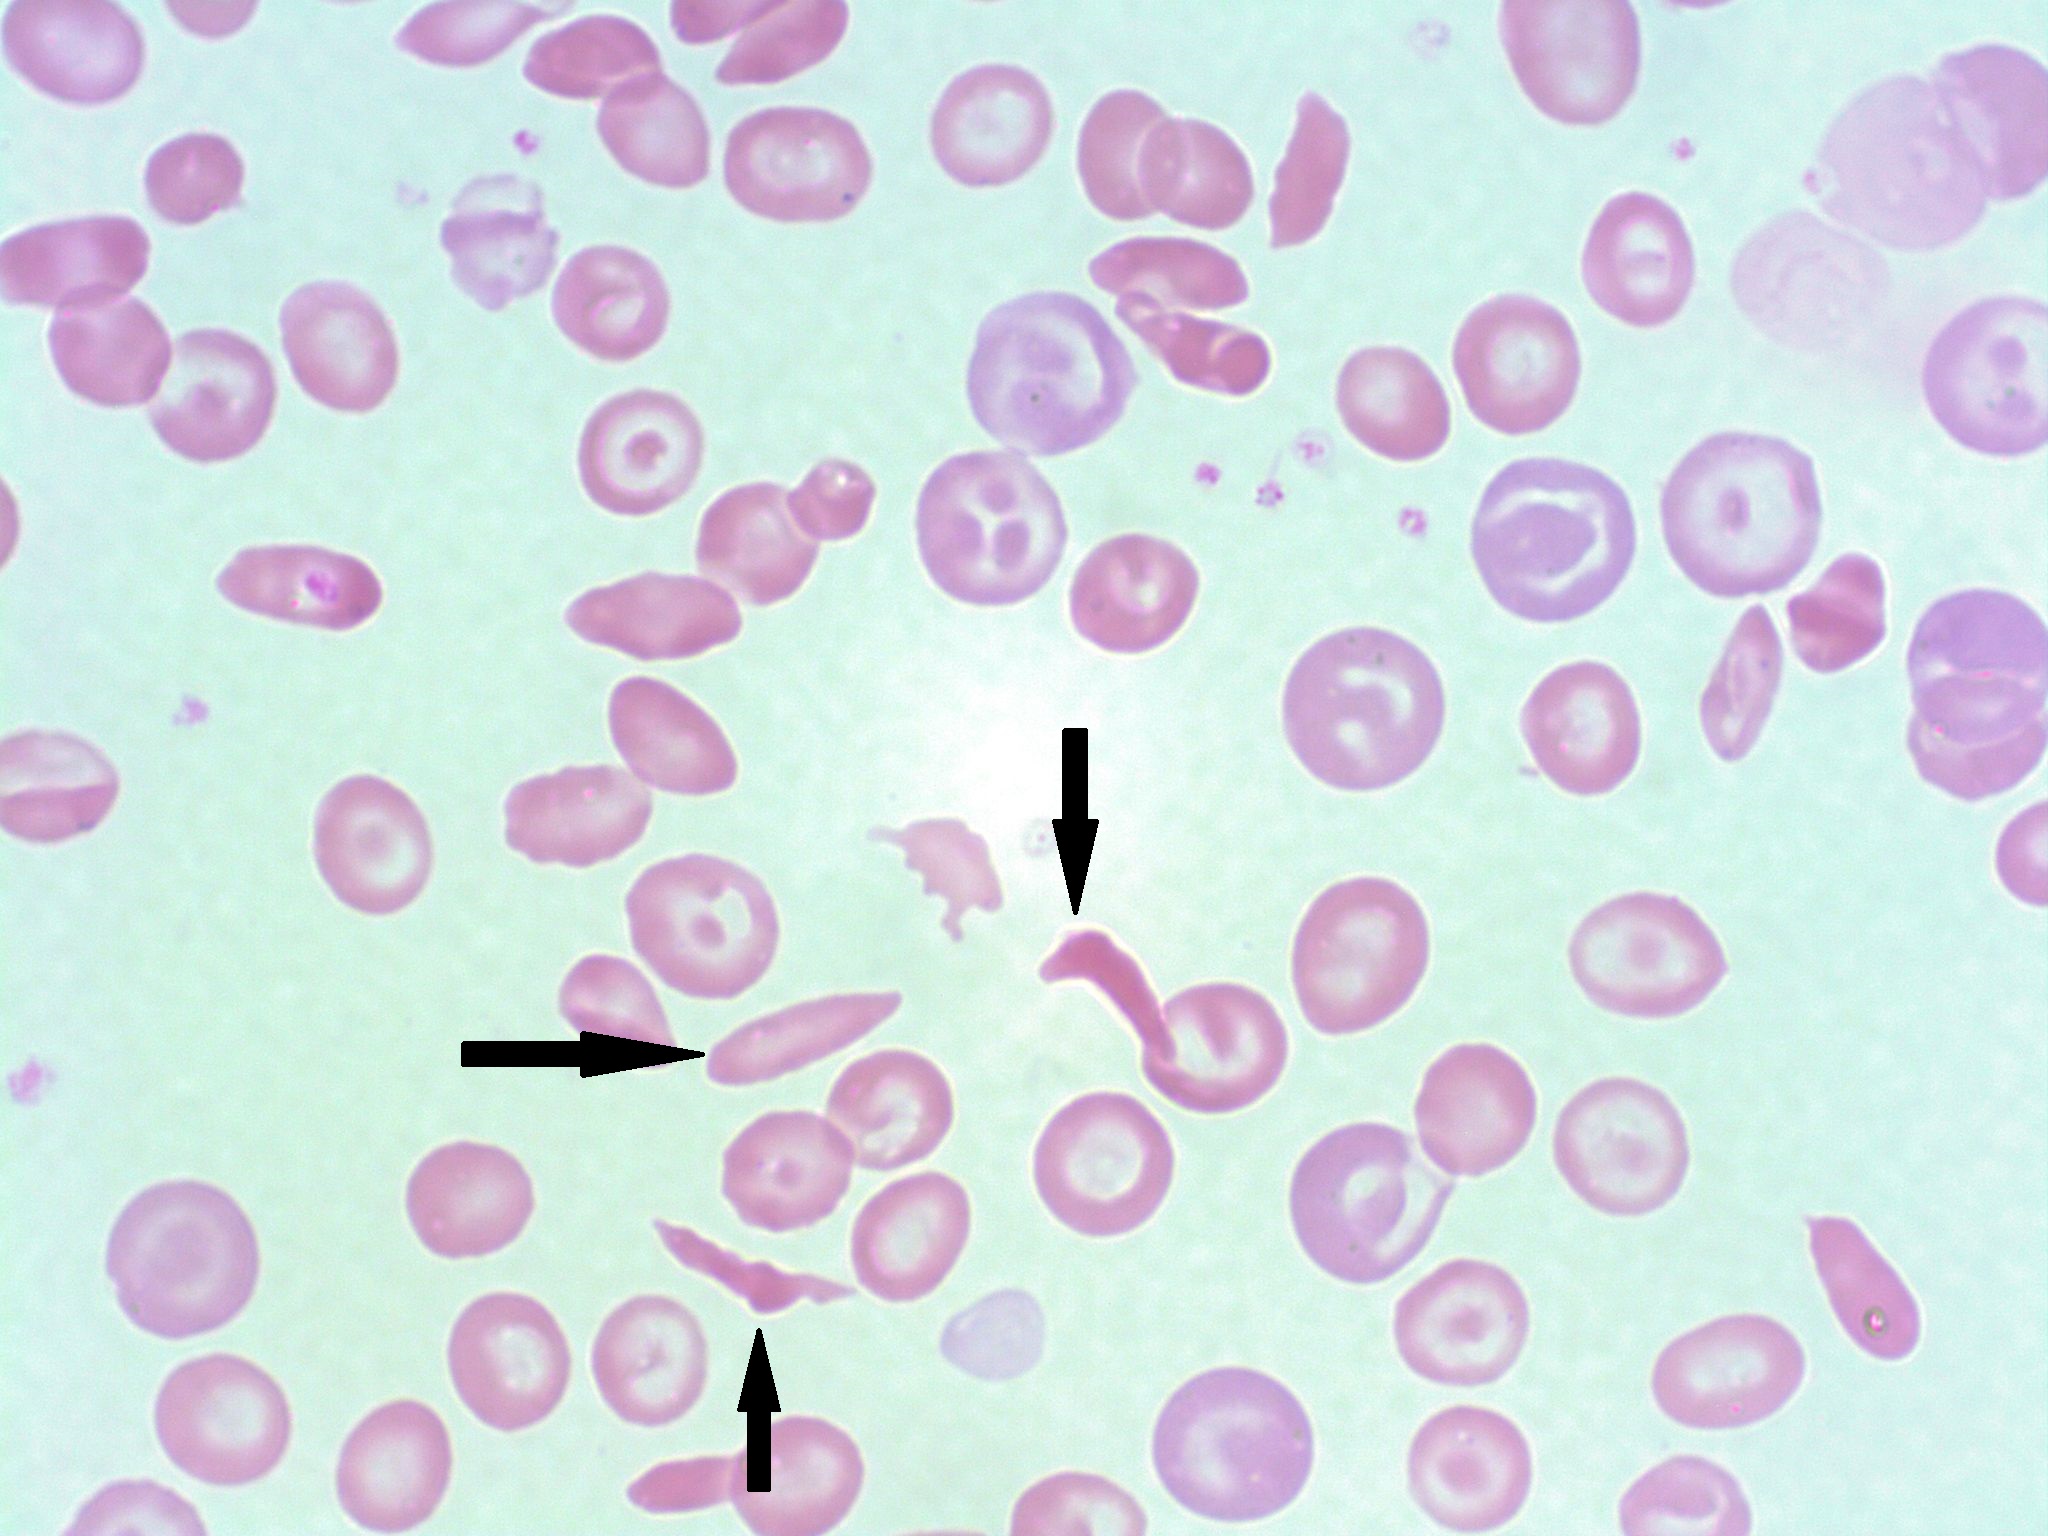

Hematology
0.0(0)
Card Sorting
1/7
Earn XP
Description and Tags
Last updated 11:36 PM on 1/5/26
Name | Mastery | Learn | Test | Matching | Spaced | Call with Kai |
|---|
No analytics yet
Send a link to your students to track their progress
8 Terms
1
New cards
red blood cell
\#1

2
New cards
monocyte
\#2
3
New cards
basophil
\#3

4
New cards
platelet
\#4

5
New cards
lymphocyte
\#5

6
New cards
eosinophil
\#6

7
New cards
neutrophil
\#7

8
New cards
sickle cell anemia
What disease is shown here?